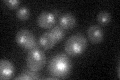
YPL075W
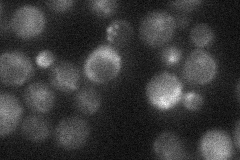
YPL075W

View description
Transcriptional activator of genes involved in glycolysis; DNA-binding protein that interacts and functions with the transcriptional activator Gcr2p
Localization:
Intensity:
Fold change:
Significance:
-
C’ GFP library in SD
nucleus22.45 -
N' NOP1pr-GFP in SD

punctate17.0854 -
N' TEF2pr-mCherry in SD

punctate,nucleus10.9819 -
N' NATIVEpr-GFP in SD
punctate21.9796 -
N' TEF2pr-VC and Cyto-VN in SD

#N/A0 -
C’ GFP library in SD+DTT

nucleus19.570.87No -
C’ GFP library in SD+H2O2

nucleus25.111.11No -
C’ GFP library in Starvation Media

nucleus23.071.02No -
C’ GFP library on the background of Pup2-DaMP

nucleus -
C’ GFP library on the background of CCT mutant

nucleus22.54191.00354No
